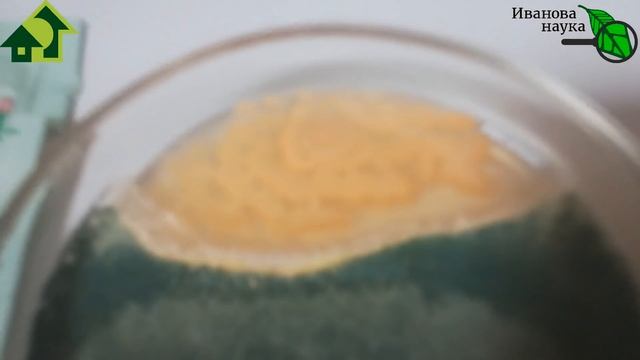
Урожай без "химии". Каким препаратам доверять? Что НЕ МОЖЕТ триходерма? Не пустышки, но... смотреть онлайн

Автор / Канал: СтройКамера Страница 6

Грунт для рассады перца, томатов и других овощных культур

Клубника Капри (земляника НСД) вторая волна плодоношения 2018г

Декор сразу на гипсокартон. #декор #декорсвоимируками #шпаклевка

Большой ремонт катера Microplus 461. Часть 8. Закатка стекломатом силового набора.

440 stainless steel plate ,polished stainless steel plate

Знакомьтесь наши индоутки

Простой, быстрый и легкий СНЕГОХОД СВОИМИ РУКАМИ | Выпуск 1 | Двигатель, рама и гусеница

Готовая работа. Dimensions Beacon at Daybreak (Маяк на рассвете)

LG пайка разбитого бака стиралки.

Реалистичная Силиконовая Маска Старика. Не Отличить От Настоящего Лица

Тел. 89255181037. Обзор автомобиля Нива ФВК-2302 "Бизон".

Легендарные советские автомобили || Ретро техника СССР под открытым небом || 3 сезон 2020 (1 серия)

Как согнуть арматуру

Елки 150 см
Урожай без "химии". Каким препаратам доверять? Что НЕ МОЖЕТ триходерма? Не пустышки, но...

Coreopsis Farm Houses 3D View

Посадка бобов в открытый грунт

Простой резак для пенопласта из подручных материалов

Пион травянистый Мунстоун (paeonia) ? пион Мунстоун обзор: как сажать рассада пиона Мунстоун

электроэрозионный прошивной

Виноград треснул 2021. Банановые Ножки!

Как выбрать мебель для ванной? Студия мебели Верес!!!

ЭЛЕКТРИЧЕСКИЙ ДРОВОКОЛ CHAMPION LSH5001H

Смотреть всем!!! Форма винограда Танго ( Калугина В.М.) на 04.09.2021 год
За каждым успешным каналом стоит личность, идея и сотни часов кропотливого труда. Если вы здесь, значит, автор «СтройКамера» уже сумел зацепить ваше внимание своим уникальным стилем или подачей. А мы на RUVIDEO позаботились о том, чтобы вы могли изучить весь архив его работ в максимально комфортных условиях — без лишней суеты и преград.
Почему за работами канала «СтройКамера» так интересно наблюдать? Всё просто: это честный контент, который находит отклик в сердцах зрителей. На нашем ресурсе вы можете смотреть онлайн все видео любимого автора бесплатно и в хорошем качестве. Нам важно, чтобы вы видели каждую деталь и слышали каждый нюанс, поэтому мы используем только стабильные плееры из открытых источников Rutube.
Следите за новинками канала, пересматривайте старые шедевры и открывайте для себя новые грани творчества «СтройКамера». Мы постоянно обновляем ленту, чтобы у вас под рукой всегда были самые свежие выпуски. Никаких сложных регистраций — только вы и творчество, которое вдохновляет. Приятного вам путешествия по миру авторского контента на RUVIDEO!
Видео взято из открытых источников Rutube. Если вы правообладатель, обратитесь к первоисточнику.